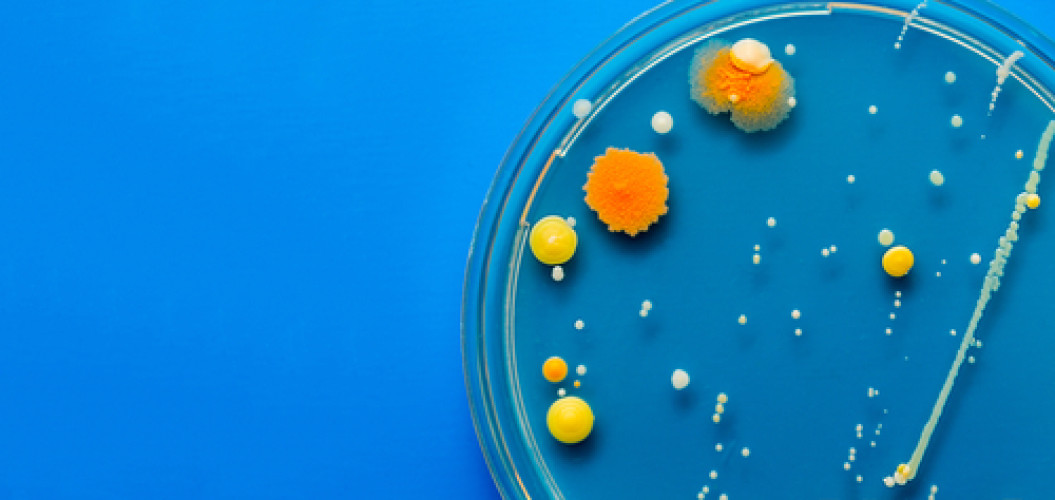

News
18.06.2021 - Analytik
Stammvergleich von Bakterien mittels MALDI-TOF
Das BAV INSTITUT bietet die Möglichkeit Bakterienstämme miteinander zu vergleichen.
Dadurch können im Fall von Kontaminationen bzw. positiven Befunden Rückschlüsse über deren Ursachen getroffen werden. Kontaminationsquellen können schneller gefunden und eliminiert werden, da man z.B. Stämme aus Endprodukten mit Stämmen aus Rohstoffen oder aus Umgebungsuntersuchungen miteinander vergleichen kann. Dieser Vergleich von Stämmen erfolgt mithilfe des MALDI-TOF Verfahrens. Auch diese Ergebnisse liegen nach der Isolierung der Stämme noch am gleichen Tag vor, so dass entsprechende Aussagen über potentielle Kontaminationsursachen sowie die entsprechenden Vorbeugemaßnahmen schnell eingeleitet werden können.
Diese Möglichkeit zum Vergleich von Stämmen isolierter Mikroorganismen ist mittels der beim BAV INSTITUT eingeführten Methoden auch bei Keimen wie z.B. Salmonellen, Bacillus cereus, Staphylococcus aureus… möglich, jedoch auch bei weiteren - sprechen Sie unsere Kundenberater für individuelle Beratungen an.
Die Ergebnisse liegen nach der Isolierung der Stämme noch am gleichen Tag vor, so dass entsprechende Aussagen über potentielle Kontaminationsursachen sowie die entsprechenden Vorbeugemaßnahmen schnell eingeleitet werden können.
Bei Fragen stehen wir Ihnen gerne zur Verfügung.